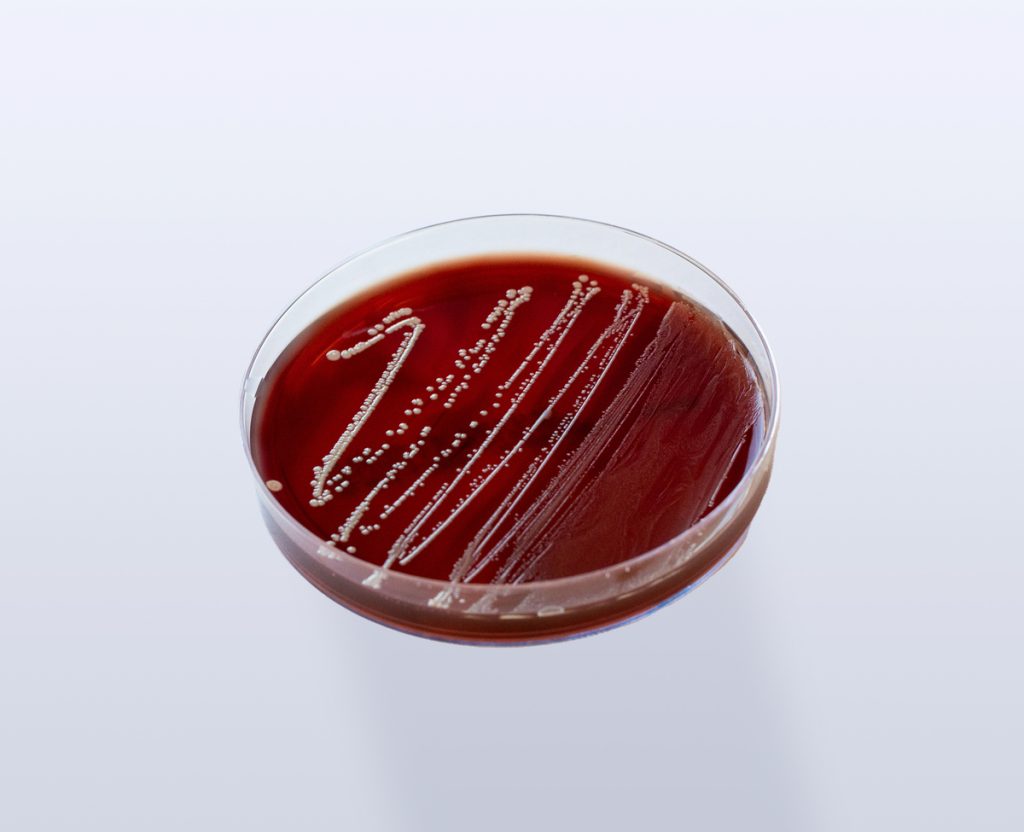

Baseado na versão 13.1 do documento do EUCAST 13-03-2023
Por: Janaina Rodrigues de Souza
Bióloga/Microbiologista
A sobrevivência de bactérias anaeróbias depende de sua sensibilidade ao oxigênio, requisitos nutricionais, coleta apropriada, meio de cultura, tempo e temperatura de incubação. Podem causar infecções graves, apresentando altas taxas de morbidade e mortalidade.
Bactérias Anaeróbias
Capazes de sobreviver e multiplicar-se na ausência de oxigênio.
A definição de anaeróbio “stricto” (estrito) , se baseia na quantidade de oxigênio que tolera, na exigência de uma tensão de oxigênio reduzida e na ausência de crescimento em superfície de um meio de cultura sólido sob uma atmosfera de 10% de CO2 (18% de O2).
O oxigênio é letal ao anaeróbio estrito porque na sua redução são formadas substâncias intermediárias tóxicas (radical hidroxila/ânion superóxido/peróxido de hidrogênio) que são removidas, eventualmente, por enzimas da família dos superóxidos dismutase e peroxidase, presentes em quantidades variáveis em algumas espécies, que assim garantem certa tolerância ao O2.
Os anaeróbios exigem, além da exclusão do O2, um ambiente com potencial de óxido-redução (Eh) baixo que pode também variar em função do pH estabelecido.
É importante salientar que esse grupo de bactérias é formado por espécies que variam de aerotolerantes a muito exigentes, quanto à ausência de oxigênio.
Infecção
As infecções por anaeróbios são causadas, principalmente por:
. Origem Endógena
Bacteroides fragilis, Bacteroides thetaiotaomicron, Parabacteroides distasonis, Peptostreptococcus spp, bacilos Gram negativos pigmentados (Prevotella spp e Porphyromonas spp.) e Fusobacterium spp.
. Origem Exógena
Clostridioides botulinum. Clostridioides perfringens, Clostridioides tetani.
Características das infecções prováveis por Anaeróbios
– Sítio anatômico da infecção localizado próximo à superfície da boca (local de colonização bacteriana);
– Surgimento de infecções após mordida de animais;
– Infecção associada a tumores;
– Odor fétido;
– Presença de gás no local da infecção;
– Presença de grânulos de enxofre no material clínico (característica de uma infecção por Actinomyces);
– Presença de bactérias no Gram (bacilos Gram-positivos esporulados que lembram Clostridium), bactérias no material clínico corado pela coloração de Gram, que não crescem nos meios de cultura mantidos em atmosferas de aerobiose;
– Crescimento de bactérias somente na parte inferior de tubos com meios de cultura em caldo Tioglicolato com resazurina;
– Ausência de resposta à terapia antimicrobiana, caso esteja sem cobertura para anaeróbios.

Coleta
A coleta adequada de materiais clínicos para a pesquisa de bactérias anaeróbias é fundamental para um diagnóstico preciso.
Transporte
Deve ser feito de acordo com o tipo de amostra, utilizando meios de cultura apropriados e mantendo a temperatura adequada.
O tempo de transporte depende do material e do volume da amostra.
– Material purulento (> 3mL), manter o tubo vedado (viabilidade por 2-3 horas);
– Tubos gaseificados (mistura de N₂, H₂ e CO₂ ou CO₂ apenas);
– Meios de transporte semi-sólidos contendo agentes redutores, como a cisteína, dispostos em camada alta (Cary-Blair pré-reduzido) – Agência Nacional de Vigilância Sanitária – Anvisa;
– Meio de cultura Tioglicolato meio semi sólido pré reduzido.
Importante:
– Não utilizar seringa, pelo risco ocupacional que representa.
– A amostra deve ser mantida entre 18 e 22ºC durante o transporte (2h).
– Não refrigerar (pois pode aumentar a difusão do O2, ocasionando perda de algumas bactérias anaeróbias).

Observação: Transportar em posição vertical, em temperatura ambiente (estabilidade de 24h).

Observação: O frasco não pode ser refrigerado.
Processamento da Cultura de Anaeróbios
– Deve ser realizado preferencialmente, em câmara anaeróbica, apropriada para laboratórios que processam grandes quantidades de cultura de anaeróbios;
– Semeados em ágar anaeróbio (materiais clínicos suspeitos) para melhor recuperação;
– O tempo de realização do preparo até a semeadura deve ser realizado em até 20 minutos.
Ágar Anaeróbio
Meio de cultura seletivo para anaeróbios (a maior parte das infecções provocadas pelos anaeróbios estritos são infecções mistas), o uso de meios de cultura seletivos auxilia no isolamento bacteriano.
Atmosfera de Anaerobiose em Laboratório Clínico
As jarras de anaerobiose com geradores químicos permitem obter uma atmosfera adequada para a multiplicação dessas bactérias. Os mais utilizados são os que provocam o consumo do oxigênio através da reação deste com o H2, gerado pela presença de um haleto, formando água. A atmosfera da jarra é substituída por CO2, gerado pela presença de bicarbonato. Utiliza-se um controle (fita de papel de filtro impregnada de azul de metileno, que é um indicador de anaerobiose).
Teste de Sensibilidade
Seguir as recomendações do BrCast/Eucast (brcast.org.br)
– Utilizar o Meio de Cultura Ágar Anaeróbio Fastidioso com 5% de Sangue de Cavalo (FAA-HB).

O Meio de Cultura FAA-HB é o recomendado para disco-difusão dos anaeróbios (BrCast/Eucast).
– Microrganismos Referência para o teste de Sensibilidade:
Bacteroides fragilis ATCC 25285
Clostridium perfringens ATCC 13124


O BrCast/Eucast estabeleceu um método para avaliar o ambiente anaeróbico para o teste de suscetibilidade antimicrobiana (AST) de bactérias anaeróbias em ágar anaeróbio fastidioso com 5% de sangue de cavalo desfibrinado mecanicamente (FAA-HB).
O método utiliza a associação entre a diminuição do diâmetro da zona do disco do metronidazol e o aumento dos níveis de oxigênio com um microrganismo referência aerotolerante de Clostridium perfringens DSM 25589 (CCUG 75076 e NCTC 14679).
O microrganismo referência C. perfringens foi testado em FAA-HB com inóculo McFarland 1 e disco de metronidazol 5 μg. FAA-HB foi incubado por 16-20 h a 35-37°C.
Foi determinada a associação entre os níveis de oxigênio (0, 0,16, 1, 2 e 4% de oxigênio) e o diâmetro da zona do metronidazol.
A reprodutibilidade a 0% de oxigênio foi investigada como parte de um estudo multicêntrico europeu de difusão em disco de bactérias anaeróbias. Os diâmetros médios da zona (n = 12) em cada nível de oxigênio foram 29mm (0%), 21 mm (0,16%), 16 mm (1%), 15 mm (2%) e 15 mm (4%). Os diâmetros da zona do metronidazol a 0% de oxigênio do estudo de reprodutibilidade multicêntrico tiveram uma mediana de 29 mm e uma faixa de percentil de 95% de 25-33 mm (n=236). Apenas uma leitura foi inferior a 25 mm. Com base nos resultados, um diâmetro de zona de ≥25 mm usando um disco de metronidazol de 5 μg e o microrganismo C. perfringens, testado com as recomendações do EUCAST, pode ser usado para indicar que o ambiente anaeróbio é de qualidade suficiente para cultura e difusão em disco AST.
O EUCAST incluiu o método como parte do Controle de Qualidade para AST de bactérias anaeróbias.
- Como fazer o controle do ambiente anaeróbio? (BrCast/Eucast):
Microrganismo Referência:
Clostridium perfringens NCTC 14679 (DSM 25589)
Agente antimicrobiano: Metronidazol (5 µI)
Intervalo >/= 25 mm.
OBS: Halo >25 mm indica um ambiente de anaerobiose insuficiente.
A Plastlabor está atenta à atualização dos documentos vigentes para melhor atender aos seus clientes.
Referências Bibliográficas
– EUCAST (European Committee on Antimicrobial Susceptibility Testing). Consultation on MIC breakpoints for additional antimicrobial agents on anaerobic bacteria (Bacteroides spp., Prevotella spp., Fusobacterium necrophorum, Clostridium perfringens, and Cutibacterium acne). Disponível em: https://www.eucast.org.
– BrCast (Brazilian Committee on Antimicrobial Susceptibility Testing). Tabelas de pontos de corte para interpretação de CIMs (Concentrações Inibitórias Mínimas) e diâmetros de halos. Disponível em: https://brcast.org.br.
– Oplustil, C. P., Zoccoli, C. M., Tobouti, N. R., & Scheffer, M. C. (Eds.). Procedimentos Básicos em Microbiologia Clínica (4ª ed.). Editora Sarvier.


